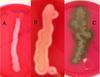
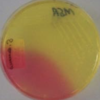
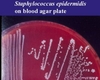

PHD - Staphylococci, Streptococci, and Enterococci (Steed) Flashcards
(123 cards)
What is an advantage of having colonies of staph epidermidis on the skin?
Protection from staph aureus and staph pyogenes cutaneous infections
Keratinocytes that are infected with staph epidermidis produce anti-microbial peptides in response to infection. This prevents other staph from infecting the skin in that area.
What is rheumatic fever and how is it related to streptococcal infection?
Rheumatic Fever is characterized by immune-mediated damage to the heart muscle.
Streptococcal cell walls and myocardial cell surface antigens have similar proteins. Antibodies against Strep will cross-react with myocardial cells, causing heart damage.
This is a form of molecular mimicry

Which bacterium is always responsible for bullous impetigo?
Staph aureus
Bullous impetigo is a less contagious version of impetigo that tends to affect the face, axillae, trunk and perianal region. It may also involve mucous membranes.

Which patient population is recommended to get vaccinated with Prevnar?
Prevnar is recommended for infants as young as 2 months and for patients over 65.
This vaccine is also recommended for immunocompromised patients, patients with organ damage, and those who go to daycare.
What are the 4 major virulence factors of streptococcus pyogenes?
- M protein
- Streptolysins O and S
- Superantigenic exotoxins
- Hyaluronic capsule

Your patient is a 3-month-old infant who presents with a red rash and desquamation of the skin of the gluteal region, legs, and upper back. What is the mechanism that caused this disease process?
A. Biofilm formation
B. Enterotoxin-mediated superantigen activity
C. Exotoxin-mediated destruction of the stratum granulosum cell-cell cohesion
D. Leukocidin activity in combination with protein A activation of TNF
E. Superantigen-mediated cytokine production

C. Exotoxin-mediated destruction of the stratum granulosum cell-cell cohesion
This child has staphylococcal scalded skin syndrome (SSSS), which is caused by release of exfoliatins A and B. These exfoliatins interfere with cell-cell cohesion molecules in the upper layers of skin, causing desquamation and redness.
B would cause non-mentrual toxic shock syndrome and food poisoning
D is a virulence factor of Staph aureus
E would cause toxic-shock syndrome
What are the main stages of biofilm formation in Staph infections?
- Attachment of planktonic cells
- Multiplication and exodus - mediated by autolysin A
- Accumulation and formation of exopolysaccharide
- Formation of mature biofilm

What is vancomycin-intermediate staph aureus (VISA) and how is this form more difficult to treat?
VISA are staph bacteria that have an intermediate resistance to vancomycin.
Chromosomal mutations –> thicker cell wall –> traps vancomycin in cell wall and prevents it from reaching its target
What are the 4 requirements for the expression of Toxic Shock Syndrome Toxin-1 (TSST-1) that are provided by the use of highly absorbent tampons?
- Elevated protein
- Relatively neutral pH (6.5 to 8)
- Elevated pCO2
- Elevated pO2
1-3 are provided by the menstrual blood. 4 is caused by the tampon itself.
Which two Lancefield System groups contain beta-hemolytic streptococci?
A and B
A (S. pyogenes) and B (S. agalactiae) are both highly pathogenic and pyogenic.

What is the morphological difference between Staph and Strep on culture?
Staph grows in clusters
Strep grows in chains
Staphylo means cluster
Strepto means chain

What are the 3 types of carriers of staph aureus and how can this make it difficult to determine carrier status?
- Persistent carrier (~20%) - carry the same strain over time
- At increased risk of infection
- Intermittent carriers (~30%) - carry different strains over time
- Difficult to determine because there are times when this individual does not have staph present
- Non-carriers (50%)
True or False: Staphylococci are able to colonize on virtually all animals.
True
Which drugs are used to treat Staphylococcus agalactiae?
- High-dose parenteral penicillin
- Ampicillin
- Ceftriaxone

What type of hemolysis does Strep pneumoniae cause and how would this colony appear on a blood agar plate?
Alpha hemolysis
Remember that alpha hemolysis is characterized by oxidation of hemoglobin to form methemoglobin. Methemoglobin appears as green on the blood agar plate.

How is the SCCmec gene different between healthcare-associated vs. community-acquired MRSA?
- Healthcare-associated has a large SCCmec gene - means it is multi-antibiotic resistant bacteria
- Community-acquired has a small SCCmec gene - means it is resistant to only methicillin and erythromycin

What is the standard drug of choice to treat streptococcus pneumoniae? What about if the bacteria are tolerant to this drug of choice?
Penicillin
If the bacteria are tolerant or moderately resistant to Penicillin, a third-generation cephalosporin (eg ceftriaxone), should be given.
A 29-year-old male presents to the emergency department complaining of back pain. Upon physical examination, you notice facial edema and a BP of 150/95. He tells you that his urine has been a dark color recently ever since he got over a strep infection. What is this condition called and would you expect to see on a histologic section of the kidney?
Acute Glomerulonephritis
Histologic section would show immune complexes within the glomeruli. These immune complexes consist of anti-strep antibodies that cross-react with self-antigen or strep-antigen.

What are the invasive infections caused by Streptococcus agalactiae in adults?
- Pneumonia
- UTIs
- Skin/soft tissue infections (w/ or w/o osteomyelitis)
- Bacteremia (w/ or w/o endocarditis)
- Meningitis
What is one way to get around the action of bacterial beta-lactamases?
Clavulanic acid
Clavulanic acid is a beta-lactamase inhibitor. Using this with penicillin or amoxicillin will help to prevent breakdown of the drug before it has a chance to work on the bacteria.
Augmentin = amoxicillin + clavulanic acid
Which specific part of the body do Staph aureus bacteria prefer to reside?
Anterior Nares
These bacteria also colonize the axillae and perineum
What are the 4 types of Microbial Surface Components Recognizing Adhesive Matrix Molecules (MSCRAMMs)?
- Protein A - binds Fc portion of IgG/IgM to inhibit opsonization and complement activation
- Clumping factor - binds fibrinogen and platelets
- Fibronectin-binding proteins
- Collagen-binding proteins
A 26-year-old female presents to you clinic complaining of pain with swallowing, a cough, and a runny nose. Upon examination, you notice that the tonsils are swollen and that there are red patches on the pharynx and uvula (seen below). What bacteria has infected your patient and what do you prescribe?

Streptococcus pyogenes
Treat with penicillin
Remember that strep. pyogenes presents as pharyngitis, skin infection, toxic shock syndrome, or necrotizing fasciitis.
What are staphylokinases and how do they contribute to staph infections?
Staphylokinases are enzymes used to break off staph cells from a cluster via fibrin lysis.
This allows single staph bacterial cells to travel and infect other parts of the body.